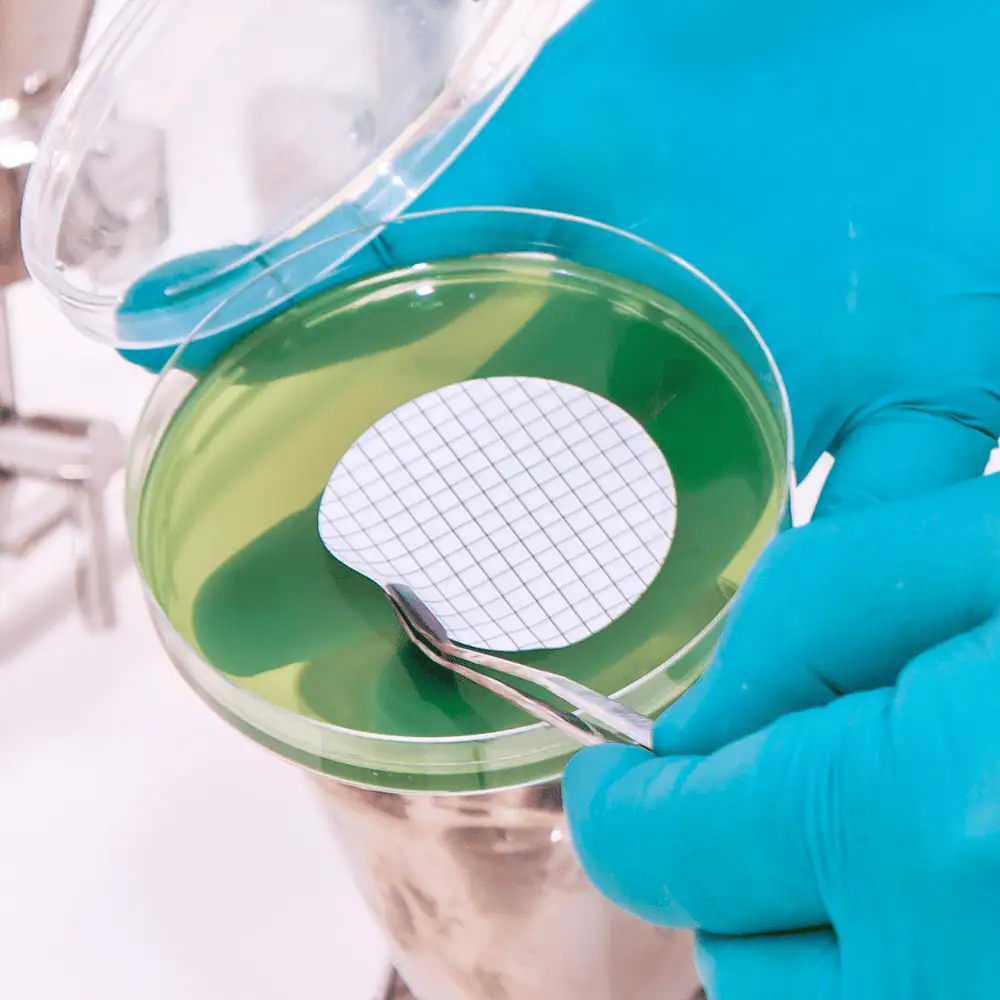

Mixed Cellulose Esters (MCE)
Nupore Mixed Cellulose Esters (MCE) membrane filters are composed of a mixture of cellulose nitrate and cellulose acetate polymers. These are hydrophilic membranes with excellent biocompatibility, superior flow rates, and high protein binding capacity.
Available in 0.45µ in both plain or gridded formats, these membranes are extensively used in microbiological analysis to support routine cell colony counting and particle detection.
Known for their uniform pore structure and high flow rates, Nupore Mixed Cellulose Esters membrane filters deliver reliable retention of bacteria, yeast, and particulates, making them ideal for water testing, sterility testing, air monitoring, and general laboratory filtration.
Operational Parameters
| Max Temp: | 80 °C Continuous |
| Typical Water Flow Rate: | 60 mL/min/cm² @ 10 psi, 27°C |
| Autoclavable: | Dry Autoclavable for 30 minutes at 121 °C |
Functional Parameters
| Thickness: | 125 - 145 micron |
| Bubble Point: | 0.45μm: ≥ 2206 mbar (32 psi) (water wetted) |
| Microbial Retention: | 0.45μm: LRV > 7 for Serratia marcescens |